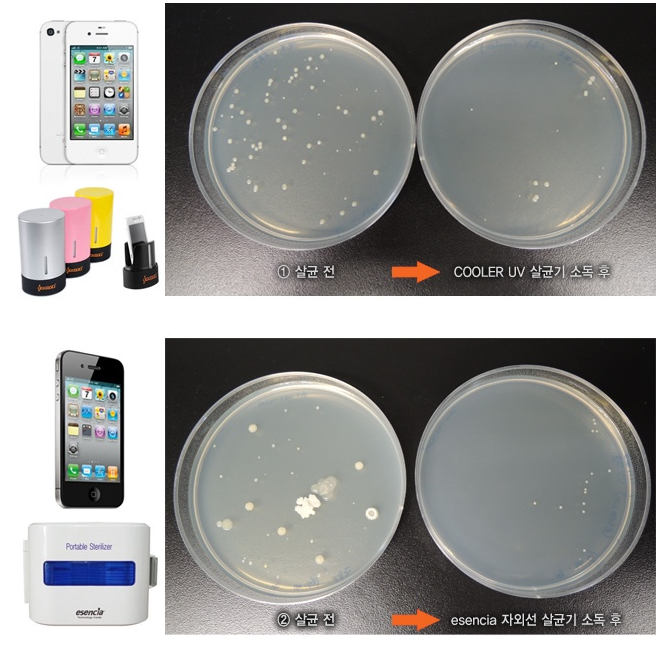

샤오미 스마트폰 살균기
정말 스마트폰에는 많은 세균이 있습니다. 오죽하면 화장실 보다 더럽다는 휴대폰 어떻게 관리하는 게 좋을까요?
한시도 스마트폰을 손에서 놓지 않아 오염도 쉽게 되는 데, 세척도 하지 않습니다. 소독욕 에탄올, 알콜 스왑, 살균 스프레이 등을 이용하여 스마트폰의 세균을 잡을 수 있습니다.
또하나 스마트폰 살균기를 이용하면 충전도하면서 스마트폰 세균도 잡을 수 있습니다. 이번에 소개할 제품은 샤오미 스마트폰 살균기입니다.
스마트폰 세균 잡는 살균기 2종을 추천합니다.
🔺 샤오미 FIVE 다용도 살균기 : https://qoo.tn/Asa2PR/Q107578318
🔺 샤오미 EUE UV 자외선 살균기 : https://qoo.tn/A1b2PR/Q107578318
2가지 제품이며 가격 대비해서 좋은 살균기 입니다. 3만원에 구매할 수 있는 샤오미 스마트폰 살균기 입니다. 스마트폰 뿐 아니라 화장품 브러쉬, 이어폰 등의 다양한 제품을 넣고 살균을 할 수 있습니다.

샤오미 살균 스마트기로 30초만에 99.99% 살균력을 보여줍니다. 스마트폰을 완전히 덮어 살균할 수 있는 파우치 형태로 되어 있습니다.


세균 측정기가 있다면 더 확인하기 쉽게지만, LED UV-C 살균램프 파장은 265 nm- 285 nm로 바이러스의 DNA를 파괴하는 강력한 파장을 보여줍니다. 코로나 바이러스나 대장균 등의 바이러스를 빠르고 쉽게 쾌속 살균을 할 수 있습니다.
얼마나 UVC 살균 LED 효과가 있을까?
UVC 살균 램프의 단점은 디스플레이 중심으로 살균이 되며, 구석구석 되지 않는다고 합니다. 하지만 거의 대부분이 살균이 됩니다.

사이즈가 172mm x 97mm x 27mm (가로x세로x두께)로 이어폰, 안경, 악세서리, 마스크 살균도 가능합니다. 다용도로 사용할 수 있습니다.


휴대하기 좋은 사이즈에 3시간 충전에 70차 살균이 가능합니다.
샤오미 살균 스마트기 위에 2개의 LED UV-C 살균램프가 있어 더욱 강력하게 살균이 됩니다. 거리도 중요한데, 가까이에서 UVC 파장을 쐬기 때문에 바이러스 파괴가 빠릅니다.
☝ 엔돌슨 TV채널 : https://youtu.be/cCfVB9G3exk
참고할만한 UV-C LED 살균램프 뽀유
그럼 손씻기, 스마트폰 살균하기을 통해서 바이러스를 없는 쾌적한 스마트폰, 손이 되길~
🔺 샤오미 FIVE 다용도 살균기 : https://qoo.tn/Asa2PR/Q107578318
🔺 샤오미 EUE UV 자외선 살균기 : https://qoo.tn/A1b2PR/Q107578318